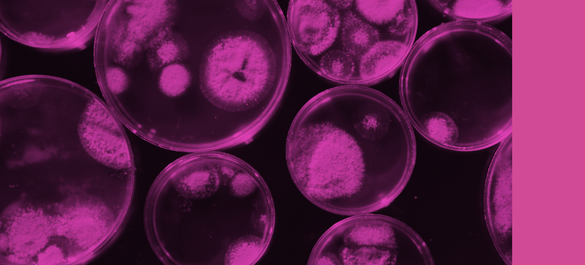
Branding used for Access Microbiology

Editorial Boards
There are six Editorial Boards that represent the Microbiology Society's journals:
- Microbiology Editorial Board
- Journal of General Virology Editorial Board
- Journal of Medical Microbiology Editorial Board
- Microbial Genomics Editorial Board
- International Journal of Systematic and Evolutionary Microbiology Editorial Board
- Access Microbiology Editorial Board
Find out more about each of the Editorial Boards and its members below:
-
Microbiology Editorial Board
Microbiology is an internationally renowned Editorial Board, led by Editor-in-Chief, Andrew Preston, University of Bath, UK. Together the Board ensure rigorous, high-quality peer review, aided by the Society’s in-house publishing team.
-
Journal of General Virology Editorial Board
Journal of General Virology welcomes high-quality research and review articles that contribute significantly to the field of virology. The Editorial Board is led by interim Editor-in-Chief, Mark Harris, University of Leeds.
-
Journal of Medical Microbiology Editorial Board
As part of the Microbiology Society portfolio, Journal of Medical Microbiology provides comprehensive coverage of medical, dental and veterinary microbiology, and infectious diseases. The Editorial Board is led by Editor-in-Chief, Tim Inglis, University of Western Australia.
-
Microbial Genomics Editorial Board
Published by the Microbiology Society, Microbial Genomics is a Gold Open Access, peer-reviewed journal publishing cutting edge, pioneering research into genomic approaches to microbiology. The Editorial Board is led by Editor-in-Chief, Samuel K. Sheppard, University of Oxford, UK
-
International Journal of Systematic and Evolutionary Microbiology Editorial Board
International Journal of Systematic and Evolutionary Microbiology is is the leading forum for the publication of novel microbial taxa and the ICSP’s official journal of record for prokaryotic names. It's Editorial Board is led by Professor Martha E Trujillo, University of Salamanca, Spain.
-
Access Microbiology Editorial Board
Access Microbiology offers the publication of replication studies, negative or null results, research proposals, data management plans, additions to established methods, and interdisciplinary work. The Editorial Board is led by Editor-in-Chief, Helina Marshall, University of Strathclyde, UK and comprised of experienced Editor Mentors who have been paired with Editor Mentees.